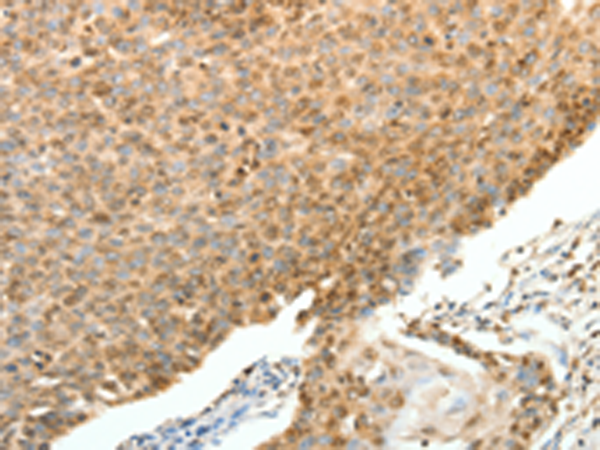
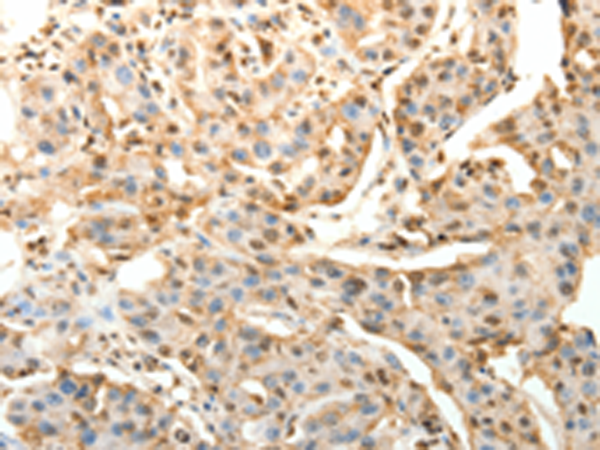
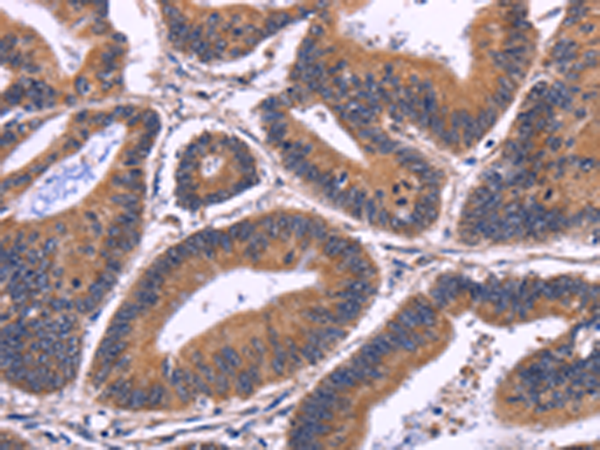

-
分类: 科研抗体货号: P07620别名: SP-D, PSP-D, SFTP4, COLEC7应用: IHC反应种属: Human
-
分类: 科研抗体货号: P07619别名:应用: WB,IHC反应种属: Human, Mouse, Rat
-
分类: 科研抗体货号: P07618别名: MAP126; DEEPEST; hMAP126应用: IHC反应种属: Human, Mouse
-
分类: 科研抗体货号: P07638别名: AIP1; API2; MIHC; CIAP2; HAIP1; HIAP1; IAP-1; MALT2; RNF49; c-IAP2应用: WB,IHC反应种属: Human
-
分类: 科研抗体货号: P07617别名: SMP1, BS-84, HSD-1, SPAG3, hSMP-1应用: IHC反应种属: Human
-
分类: 科研抗体货号: P07637别名: API1, MIHB, HIAP2, RNF48, cIAP1, Hiap-2, c-IAP1应用: WB,IHC反应种属: Human, Mouse
-
分类: 科研抗体货号: P07616别名:应用: WB,IHC反应种属: Human, Mouse
-
分类: 科研抗体货号: P07634别名: IQCH, MSRG11, MSRG-11, RP11-144C20.1应用: WB,IHC反应种属: Human
-
分类: 科研抗体货号: P07615别名:应用: WB反应种属: Human, Mouse
-
分类: 科研抗体货号: P07633别名: HSD3; LCA3; HSD-3.1; HEL-S-296应用: WB,IHC反应种属: Human

鄂公网安备42018502007531号
鄂公网安备42018502007531号

